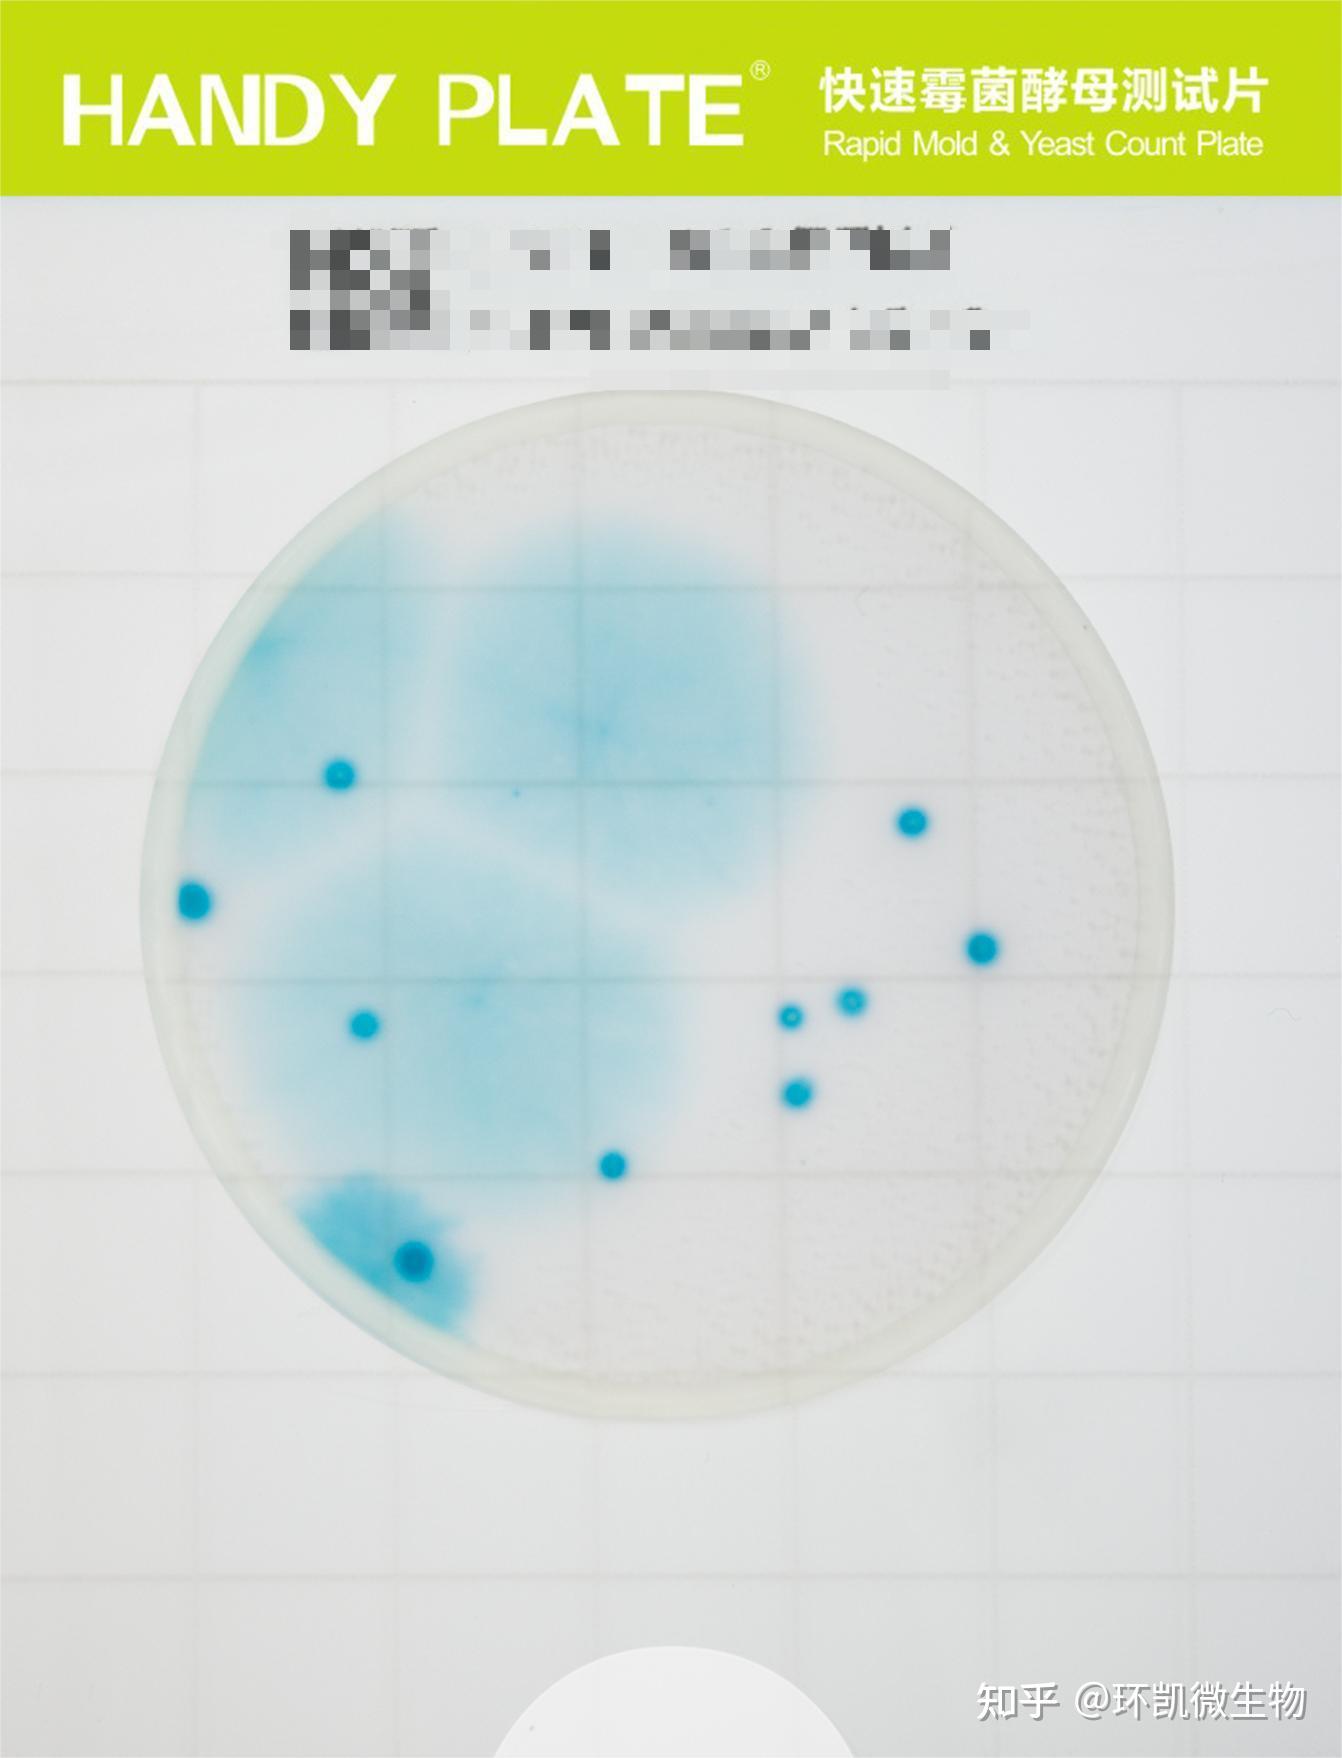

Liebherr Sn T 3 6303 4 are a flexible and convenient service for remaining arranged and efficient. From calendars and planners to to-do lists and worksheets, these templates cater to various personal and expert requirements. They are personalized, permitting you to tailor them to your preferences and make planning more effective. Whether you need a weekly schedule, spending plan tracker, or meal planner, you'll discover a style that suits your design and purpose.
Downloading and printing these templates is easy and available. Use them at home, in the office, or even on the go to simplify your daily jobs. Conserve time and effort with ready-to-use designs that streamline your regimen while adding a touch of imagination to your organization. Explore a wide variety of Liebherr Sn T 3 6303 4 today and take the primary step towards a more organized and productive lifestyle!
Liebherr Sn T 3 6303 4
Liebherr Sn T 3 6303 4
Here you can access a collection of free printable blank calendars available in various colors and formats Plan your year in style with a personalized calendar from Canva's selection of stunning templates you can customize.
Printable Calendar 2024 Free Blank and Customizable
Pump Grundfos PDF Pump Electric Motor
Liebherr Sn T 3 6303 4Free printable blank calendars are provided to print and download. Blank 2025 calendar templates are well formatted pages. Free yearly, weekly & monthly ... Yearly weekly or monthly design your perfect 2024 calendar in seconds for free Start with Word PowerPoint and Excel templates and use powerful AI
These easy no-prep printables are perfect to get your months organized on beautiful pastel colours! These templates are easy to use, easy to print and easy to ... Refrigeratorsfreezers
Free and customizable calendar templates Canva

Elektro Wildbihler Elektrofachgesch ft Liebherr Ersatzteile
On this site we provide free blank calendar printable yearly monthly and weekly calendar 2024 2025 in MS WORD DOC DOCX MS EXCEL XLS XLSX PDF and PNG Historical Linguistics Ppt Download
Each month in 2024 as a separate page Free downloadable and printable 2024 calendar PDFs All sizes even big 11x17 poster and legal size Cr pine Etoile AQUA PUR Tunisie IFU 6300 6301 6302 6303 6304 6305

S Blends SN SP ST SH SK SW Consonant Blends Letter S

194 026 Tomale Levy Music Collection

194 026 Tomale Levy Music Collection

194 026 Tomale Levy Music Collection

Consonant Blends Teach Blends With Free Decodable Passages 58 OFF

Jancy Wong Fotop Photo Sharing Network

Frigider LG No Frost

Historical Linguistics Ppt Download
Nokia 6303 Repair IFixit